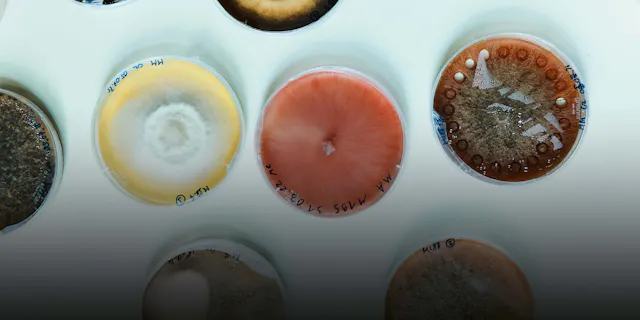

“My dream is to make medicines that help people”
Platform pioneer.

Raising awareness for clinical trials
Interview with David Soergel.

Technology for the heart
Scaling up.

A blip with heartfelt consequences
Following a hint.

Building a drug
Chemistry and physics for geeks.

Overcoming drug resistance
Never give up.

A phone call with consequences
The power of communication.

Targeting transformative treatments
Global drug development.

A complex cascade of collaboration
The making of a drug.

Nurturing a breakthrough mindset
How do you change the course of medicine?

The home of explorers
The school lab scrolly.

Time-saving tubes
Sample sending simplified.

Candidates from the cauldron
Cultivating germs.

Bringing collaboration to the next level
The Campus in a single building.

Looking for the big picture
An intrapreneur journey.

An international startup launchpad
Swissnex’ success story.
Pilar and the Petri dishes
The fabulous world of fungi.

Galactic romanticism
A collection of bold research projects.

Elements of scientific success
Overcoming a political earthquake.

Concrete innovation
Prestige investments into R&D.

Collective strength
Bringing academia and industry together.

Jumping into the unknown
A microscope with universal appeal.

On the shoulders of crowds
The work of 8 million scientists.

Enlightening the brain’s circuitry
Shedding light on gray matter.

A close look at myopia
Sensors for better vision.

Look to the future
A vision hacker.
Shorts
Our stories in shortform

Browse back issues
Download past issues of liv magazine.
Access to downloadable PDFs
Live Magazine – Science, made human
Discover the story behind Live Magazine, Novartis’ global publication launched in 1996 and now available in four languages. Explore how it evolved into a digital platform in 2020, sharing insights and innovations from across the company.
Learn more
About live magazine
Live magazine has been the in-house magazine of Novartis since 1996. It is available to the general public since 2020.
Associates/Pensioners
Associates in Switzerland and pensioners can receive the Forum supplement with birthday and other data via email. Please write to live.magazine@novartis.com, providing your name and personnel number.
Get our Updates
Stay connected by subscribing to our newsletter
By submitting your email, you consent to Novartis AG collecting and processing your email data for Novartis internal use, in accordance with our privacy policy, and by protected technical means.






























